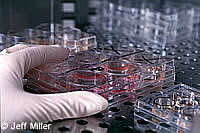

Spanische Vorschläge für Stammzellenforschung rufen zu Gesetzesänderung auf
Während die Europäische Kommission die weitere Ausarbeitung ihres Standpunktes zur Stammzellenforschung vorbereitet, hat eine maßgebliche spanische Beratergruppe dazu aufgerufen, das aktuelle spanische Gesetz zu ändern, um es Wissenschaftlern zu ermöglichen, embryonale Stammzellen für Therapie- und Forschungszwecke zu erhalten, vorausgesetzt Expertenausschüsse genehmigen dies und die Eltern des Embryos stimmen zu. In der Erklärung über embryonale Stammzellen, die von einer Meinungsbildungsgruppe der Beobachtungsstelle für Bioethik und Recht, die ihren Sitz im Parc Científic de Barcelona hat, vorbereitet wurde, heißt es, dass "die Forschung über die Nutzung von embryonalen Stammzellen zur Erzeugung verschiedener Gewebearten oder sogar einfachen Organen ein großes Versprechen für die Medizin der Zukunft birgt". Sie besagt, die Nutzung von Stammzellen aus menschlichen Embryonen für therapeutische und Forschungszwecke sei akzeptabel, wenn die Stammzellen von überzähligen Embryonen stammen, die für den Zweck der wissenschaftlichen Forschung gespendet wurden, oder von nicht übertragbaren In-vitro-Embryonen oder von eingefrorenen Embryonen, die die gesetzliche Frist für die Kältekonservierung überschritten haben. Außerdem heißt es darin, dass Stammzellen aus somatischen Embryonen, die mittels Kerntransplantation produziert werden, oder Stammzellen von speziell geschaffenen gametischen Embryonen mit der auf Sachkenntnis beruhenden Zustimmung des Gamozyt-Spenders erlaubt sein sollten. Die Erklärung der Gruppe tritt für die Schaffung gametischer Embryonen zum Zweck der Gewinnung von Stammzellen ein, wo es nicht möglich ist, überzählige Embryonen, die für Forschungszwecke gespendet wurden, zu nutzen oder diese aus oben genannten Gründen nicht zur Verfügung stehen. Sie besagt, die Gewinnung von embryonalen Stammzellen auf diese Weise sei vertretbar, da "es keinen Beweis gibt, dass in jeder Hinsicht gleiche Ergebnisse erzielt werden können, wenn fötale Stammzellen oder Stammzellen von Erwachsenen genutzt werden". Die Bewertung, Regulierung, Genehmigung und Kontrolle der Embryonenforschung, einschließlich aller Projekte, die die Nutzung von Embryonen beinhalten, sollte von einer kompetenten Behörde durchgeführt werden. Außerdem ruft die Erklärung zur Stärkung der Stammzellenforschung durch öffentliche und private Finanzierung auf, "da sonst die Gewinne in den Händen privater Unternehmen bleiben". In Spanien wird die Stammzellenforschung durch zwei nationale Gesetze geregelt, eines über unterstützte menschliche Reproduktionstechniken (1988) und eines über die Überlassung und Nutzung von Embryonen und Föten (1988), sowie durch das Menschenrechtsübereinkommen zur Biomedizin des Europarats, das von Spanien 1999 ratifiziert wurde, und zwei Urteile des Verfassungsgerichts. Das Gesetz über unterstützte Reproduktionstechniken besagt, dass innerhalb der ersten 14 Tage mit der Zustimmung des Erzeugers Forschung zu angewandten diagnostischen oder therapeutischen Zwecken durchgeführt werden kann. Nicht-therapeutische Forschung ist nur an nicht lebensfähigen Embryonen erlaubt und wenn sie nicht an einem Tier durchgeführt werden kann. Im Juni 1999 veröffentlichte der spanische Expertenausschuss für Klonen einen Bericht, der eine Gesetzgebung unterstützt, die das bestehende Verbot des Klonens aufhebt, um so die Schaffung von Gewebe zur Heilung bestimmter Krankheiten zu erlauben. Der Ausschuss war jedoch streng gegen eine Gesetzgebung, die das reproduktive Klonen von Menschen erlaubt. Die Gruppe wurde gebildet, um die ethischen, sozialen und rechtlichen Implikationen der neuen Biotechnologie-Verfahren zu untersuchen und spezifische Vorschläge für eine Gesetzgebung zu unterbreiten. Die Gruppe wurde von Dr. Josep Egozcue, einem medizinischen Spezialisten für menschliche Reproduktion, und von der Juristin Dr. María Casado koordiniert. Spezialisten für Zellbiologie und Embryologie, Medizin, Philosophie, Anthropologie und Recht leisteten Beiträge.